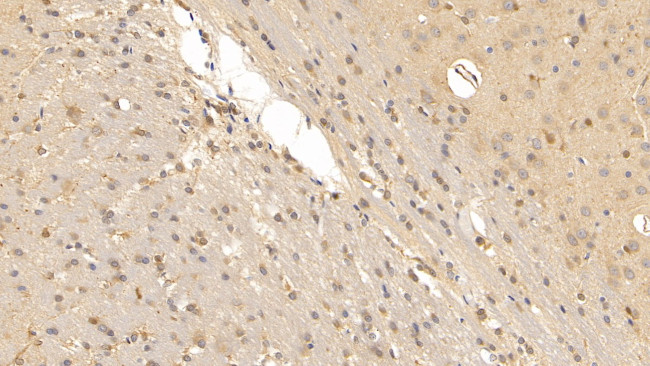
Relaxin 3 Antibody in Immunohistochemistry (Paraffin) (IHC (P))

Search
Invitrogen
Relaxin 3 Monoclonal Antibody (D10)
{{$productOrderCtrl.translations['antibody.pdp.commerceCard.promotion.promotions']}}
{{$productOrderCtrl.translations['antibody.pdp.commerceCard.promotion.viewpromo']}}
{{$productOrderCtrl.translations['antibody.pdp.commerceCard.promotion.promocode']}}: {{promo.promoCode}} {{promo.promoTitle}} {{promo.promoDescription}}. {{$productOrderCtrl.translations['antibody.pdp.commerceCard.promotion.learnmore']}}
图: 1 / 6
Relaxin 3 Antibody (MA5-41667) in IHC (P)






Please note: We are reviewing Western blot images included in the antibody testing data in our catalog, including those provided by third parties. Unless expressly labeled or annotated as “raw-unedited”, Western blot images included in the antibody testing data in our catalog may have been edited, optimized or otherwise adjusted for presentation.
产品信息
MA5-41667
种属反应
宿主/亚型
分类
类型
克隆号
抗原
偶联物
形式
浓度
规格
纯化类型
保存液
内含物
保存条件
运输条件
RRID
靶标信息
Relaxin 3 is part of the Relaxin-like peptide family that plays an important neuropeptide signaling role. Relaxin 3 is a ligand for two structurally related G protein-coupled receptors, human Relaxin receptor 3 and Relaxin receptor 4. The greatest levels of Relaxin 3 expression occur in the brain, specifically in the pons/medulla, with highest levels in the pars ventromedialis of the dorsal tegmental nucleus and with lower levels in the hippocampus and olfactory regions. Significant expression is also observed in the spleen, thymus, lung and ovary. Relaxin 3 inhibits Forskolin-stimulated cAMP accumulation in a dose-dependent manner in cells that express Relaxin receptor 3. Acute and repeated administration of Relaxin 3 causes a decrease in levels of the plasma thyroid stimulating hormone, suggesting that Relaxin 3 may play a role in long-term control of food intake.
仅用于科研。不用于诊断过程。未经明确授权不得转售。
篇参考文献 (0)
生物信息学
蛋白别名: insulin-like 7; Insulin-like peptide 7; Insulin-like peptide INSL7; PRO20213; Prorelaxin H3; Prorelaxin R3; Relaxin-3; UNQ6188
基因别名: INSL7; RLN3; RXN3; UNQ6188/PRO20213; ZINS4
UniProt ID: (Rat) Q8BFS3
Entrez Gene ID: (Rat) 266997